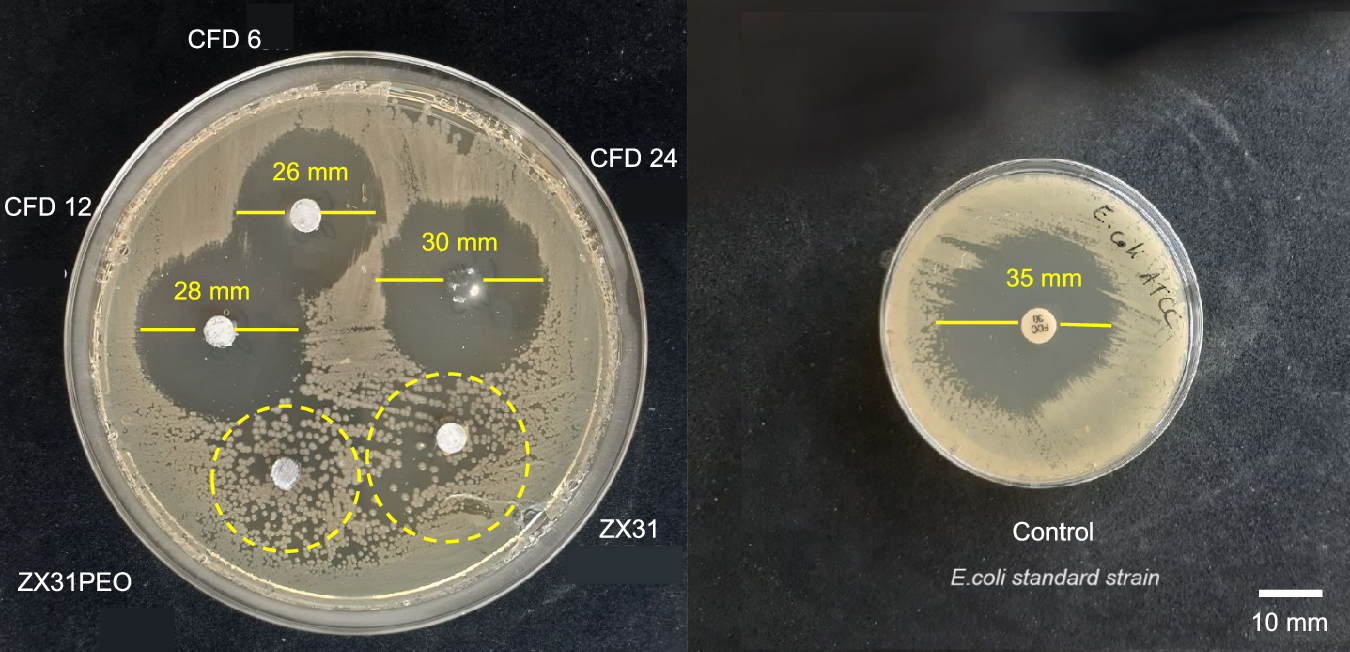
Fig. 3: Disk diffusion test of the samples with and without nanofibres.

Fig. 3: Disk diffusion test of the samples with and without nanofibres.

Antibacterial disk diffusion test results of ZX31, ZX31PEO, CFD 6, CFD 12, CFD 24, and control sample against E. coli.
Antibacterial disk diffusion test results of ZX31, ZX31PEO, CFD 6, CFD 12, CFD 24, and control sample against E. coli.